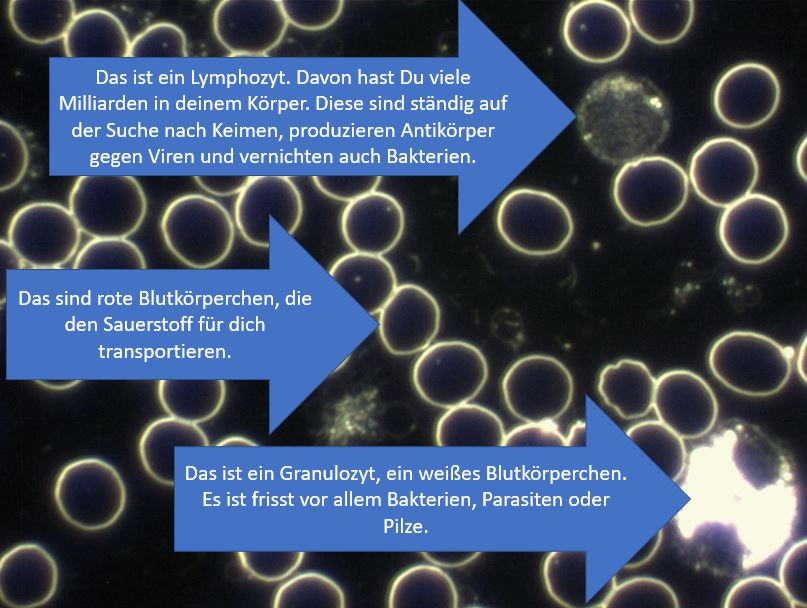
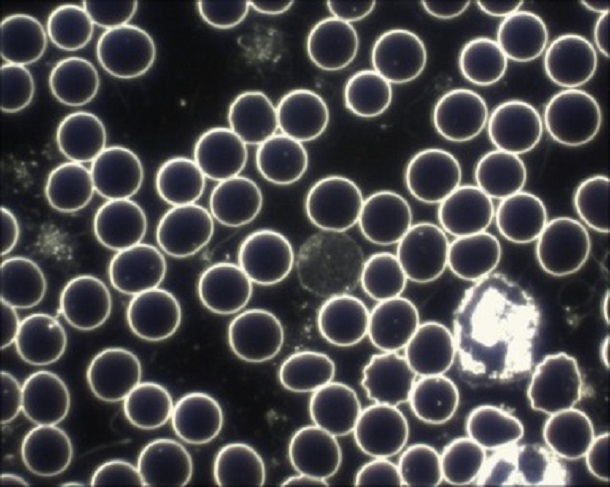

Dunkelfeldmikroskopie – Was ist das? Beispiel und Unterschied zur “normalen” Mikroskopie
Bei der Dunkelfeldmikroskopie handelt es sich um ein relativ beliebtes Diagnoseverfahren in der Alternativmedizin. Bekannt wurde es in der Humanmedizin durch den Zoologen und Entomologen Prof. Dr. Günther Enderlein.
Die Dunkelfeldmikroskopie gehört zunächst einmal in die Verfahren der Durchlichtmikroskopie. Anders als in einem Hellfeldmikroskop kann man die Dunkelfeldmikroskopie eher mit der Sicht in einer sternenklaren Nacht vergleichen: Denn hier sieht man mehr von der Vielfalt des Universums, als beispielsweise bei Tageslicht. Denn bei Tageslicht werden die Sterne von der Sonne „überstrahlt“- ebenso wie bei einem Hellfeldmikroskop.
Hier ein Beispiel:


Beim Betrachten der beiden Aufnahmen sehen Sie den grundsätzlichen Unterschied. Um beim Beispiel „Himmel“ zu bleiben: Selbst wenn der Himmel wolkenlos ist, sieht man mit dem bloßen Auge nur die Sonne, vielleicht noch den Mond. Die umliegenden Sterne bleiben dem Auge verborgen – eine Metapher, die das grundsätzliche Prinzip der Dunkelfeldmikrokopie auch für Laien sehr anschaulich erklärt.
Das Dunkelfeldmikroskop: Funktion, Besonderheiten und Vorteile
Das Besondere bei der Dunkelfeld-Diagnostik: Es gelangt nur das Licht ins Mikroskopbild, welches seitlich an den im Blut befindlichen Strukturen vorbei scheint. Somit heben sich alle Präparate im Blut durch das Mikroskopbild ab.
Man sieht also alles, was im Blut vorhanden ist, ohne dem Körper vorher etwas zufügen zu müssen, um diese sichtbar zu machen. Daher lassen sich auch lebende Organismen und Lebewesen schonend und sehr gut durch das Dunkelfeldmikroskop erkennen. Heute wird die Dunkelfeldmikroskopie nicht nur bevorzugt in der Biologie, beispielsweise bei der Beobachtung von mit dem bloßen Auge nicht sichtbaren Wasserlebewesen, verwendet, sondern immer öfter auch in der Medizin.
Übrigens: Wenn Sie solche Informationen interessieren, dann fordern Sie unbedingt meinen kostenlosen Praxis-Newsletter “Unabhängig. Natürlich. Klare Kante.” dazu an:
Für das Verfahren werden keine Kontrastmittel oder Fixierer benötigt, um mögliche Krankheitserreger oder andere Schadstoffe im Blut sichtbar zu machen – und genau hier liegt einer der größten Vorteile der Dunkelfeldmikroskopie. Da dem Blut vor der Betrachtung nichts zugeführt werden muss, nennt man dieses Verfahren auch Vitalblut-Untersuchung: man sieht das „lebende“ Blut und dessen Bestandteile.
In dieser Aufnahme habe ich für Sie einige Blutbestandteile beschrieben, die Sie im Dunkelfeld sehen können.
Das Blut wird hierbei bevorzugt aus dem Finger oder dem Ohrläppchen entnommen und es genügt oftmals ein einziger Tropfen.
siehe auch: Blutwerte
Blutbild beobachten und den Gesundheitszustand bewerten
Bei der Dunkelfeldmikroskopie wird nicht immer und direkt nach einer Abweichung, einem speziellen Erreger oder einem Krankheitsbild gesucht, sondern das Blutbild wird genau betrachtet und beobachtet – meistens über mehrere Stunden hinweg. So werden auch geringe Abweichungen, etwa Veränderungen der Blutkörperchen, sichtbar.
Im Folgenden habe ich einige Aufnahmen mit Objekten und “Zuständen”, die durch Therapeuten abgeklärt werden können:

In dieser Aufnahme (ca. 20 Minuten nach Abnahme), sehen Sie, dass die roten Blutkörperchen nicht mehr alle ganz “rund” sind. Zudem sehen wir zunehmend mehr kleine “Striche” / Stäbchen die sich bilden.

Hier wird es schon schwieriger. Die roten Blutkörperchen liegen jetzt nicht mehr nebeneinander getrennt (siehe oben), sondern liegen jetzt eher senkrecht zusammen wie bei einer Geldrolle. Dieses Phänomen wird generell als “Übersäuerung” oder “Darmbelastung” gewertet, aber ich rate zur Vorsicht mit vorschnellen Diagnosen. Es kann auch einfach ein Blutentnahme-Fehler sein.
Das Problem der Dunkelfeldmikroskopie ist, wie diese Veränderungen im Blut (die bei der mehrstündigen Betrachtung auftreten) zu bewerten sind.
Die vorhandene Literatur stützt sich auf wenige Anwender, die verschiedene Phänomene beschreiben und teilweise zu unterschiedlichen Aussagen kommen.
Fazit: Die vorhandenen Phänomene und Veränderungen im lebenden Blut nach dessen Abnahme werden nur im Dunkelfeldmikroskop sichtbar. Leider werden diese Phänomene von der Schulmedizin weitgehend ignoriert und nicht weiter beachtet.
Es wäre zu wünschen durch gezielte Forschung die Dunkelfeldmikroskopie weiter zu entwickeln.
Zum Schluss noch ein abschreckendes Beispiel von Dunkelfeld-Aufnahmen.
Folgendes Bild wurde u.a. auf telegram geteilt:

Wir sehen hier in deutlich geringerer Vergrößerung auch Blut. Allerdings sehen wir hier vor allem den Rand des Bluttropfens (oben). Die Ränder sehen mehr oder weniger fast immer so aus. Was wir hier allerdings sehen ist ein stark verschmutzter Objektträger (helle Objekte ganz oben). Zudem sehen wir Lufteinschlüsse im Präparat.
Das könnte man alles als “Anfänger-Fehler” bezeichnen. In der Praxis würde ich einem Assistenten anweisen, diese Probe zu verwerfen und eine neue Entnahme durchzuführen.
Aber wir haben noch das Problem, dass solche Bilder gezeigt werden und behauptet wird, dass hier die Folgen einer Corona-Impfung deutlich zu sehen seien, inklusive Nanotechnologie, usw. Ich halte das für blanken Unsinn, dies aus diesem Bild hier abzuleiten.
Indes: es gibt “vernünftige” Aufnahmen, welche die Problematik bei Patienten zeigen, die nach Corona-Impfungen mit Problemen zu tun hatten.
Übrigens: Wenn Sie solche Informationen interessieren, dann fordern Sie unbedingt meinen kostenlosen Praxis-Newsletter dazu an:
Dieser Beitrag wurde erstmalig im Jahr 2014 erstellt und letztmalig am 11.7.2023 ergänzt und überarbeitet.